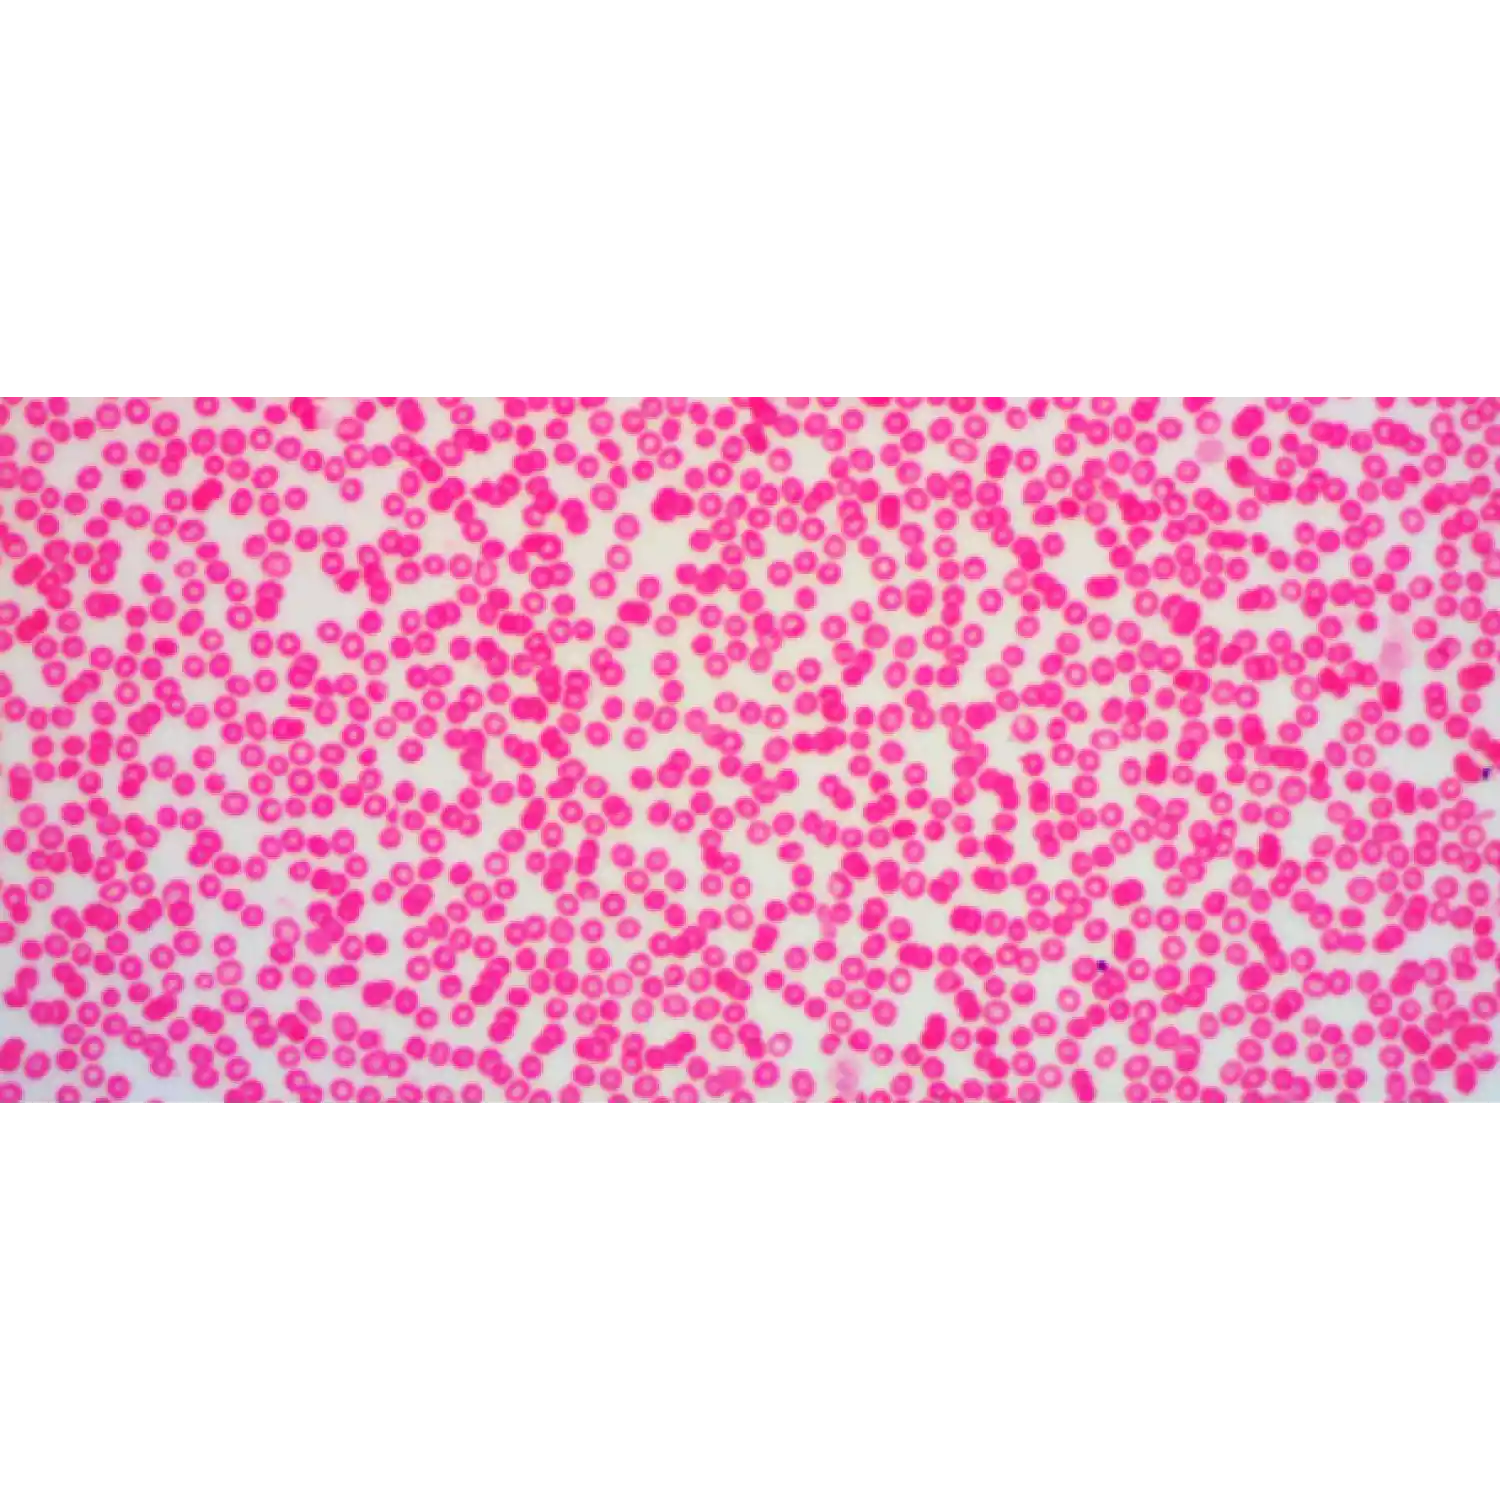

Микроскоп цифровой Levenhuk D670T, 5,1 Мпикс, тринокулярный
Увеличение: 402000x. В комплекте цифровая камера 5 Мпикс, конденсор Аббе и ирисовая диафрагма
- Гарантия: пожизненная
- Вес в упаковке: 5.75 кг.
- Размер упаковки (ДхШхВ): 37.0×22.0×42.0 см.
Микроскоп Levenhuk D670T, 5,1 Мпикс, тринокуляр современный, удобный и надежный цифровой микроскоп с тринокулярной насадкой. Такая насадка обеспечивает максимальный комфорт при длительных наблюдениях. 5-мегапиксельная камера позволяет получать изображения превосходного качества, вы сможете внимательно изучить увиденное в реальном времени на экране вашего ПК, а также сохранить изображение для дальнейшего использования.
Микроскоп дает увеличения в диапазоне от 40 до 2000 крат. и имеет высокую разрешающую способность. Он прекрасно подойдет для медицинских или лабораторных исследований, позволит эффективно работать с микропрепаратами и детально изучать прозрачные образцы. Прибор комплектуется качественными объективами 4x, 10x, 40x и100x (Oil).
Подключив камеру к тринокулярной насадке, вы получаете для исследования полноценный бинокулярный микроскоп, который поможет снизить нагрузку на глаза (в сравнении с монокулярными моделями), тем самым продлив время исследования. Для дополнительного комфорта насадка имеет удобный угол наклона в 30 градусов; также она оборудована поворотным механизмом на 360 градусов, что очень удобно при групповых исследованиях.
В комплекте с микроскопом поставляется не только цифровая камера, но и все необходимое программное обеспечение (русифицированное для Windows) и драйверы. Микроскоп Levenhuk D670T совместим с операционными системами Mac OS, Linux 2.6*, Windows XP/Vista/7/8/10, для подключения необходим порт USB 2.0.
* Драйвер для Linux собран под Ubuntu10.04 с ядром 2.6.32-50-generic-pae.
Если приложение не запускается на вашей платформе или символы искажены, обратитесь к нам, указав платформу и версию ядра.
Внимание! Помните, что напряжение сети в России и большинстве европейских стран составляет 220-240 В. Если вы хотите использовать устройство в стране с другим стандартом сетевого напряжения, необходимо включать его в розетку только через соответствующий конвертер (преобразователь напряжения).
Особенности:
- В комплекте цифровая камера 5 Мпикс
- Совместим с операционными системами Windows, Mac, Linux
- Русифицированное программное обеспечение (только для Windows)
- Увеличение микроскопа: 40-2000x
- Поворотная тринокулярная насадка
- Превосходное качество изображения по полю
- Предметный столик с координатным перемещением
- Револьвер на 4 объектива
- Плавная регулировка освещенности
Оформить покупку в интернет-магазине. Вам необходимо добавить продукцию в электронную корзину, заполнить короткую заявку и отправить её нам.
Обратится к специалистам «А3 Инжиниринг». Написать на электронную почту, в WhatsApp, или позвонить по номеру телефона. Указать какая товарная позиция вас интересует, а также количество единиц, и получить счет на оплату.
Посетить наш офис, где можно протестировать продукцию, а после оформить заказ.
Наша компания работает с надёжными курьерскими службами, ответственными транспортными компаниями, что позволяет организовать обслуживание клиентов на высшем уровне. Доставка осуществляется по всей территории РФ, Казахстана и Беларуси.
Вы сами выбираете подходящую компанию для получения товара − «Деловые линии», ПЭК, СДЭК «СПСР-экспресс», DHL, «Курьер Сервис», «Грузовозофф». Стоимость доставки зависит от удалённости пункта назначения от нашего склада.
Пункт выдачи СДЕК в г. Москва: Нагорный проезд д.7 стр. 1.
Мы принимаем оплату безналичным способом. Вам необходимо осуществить перевод средств на расчётный счёт нашей компании. Все документы будут подготовлены максимально быстро − за 60-90 минут.
Вместе с продукцией вы получаете:
- оригинал выставленного счёта;
- товарную накладную;
- счёт-фактуру.
Также к товару прилагаются официальные документы − инструкция, гарантийный талон, свидетельство о калибровке или поверке, если эти процедуры проводились. Узнать больше можно, позвонив нам по номеру +7 (800) 500-59-46.
Уточнить цены можно по телефону +7 (495) 120-07-46 или по эл. почте info@a3-eng.com.